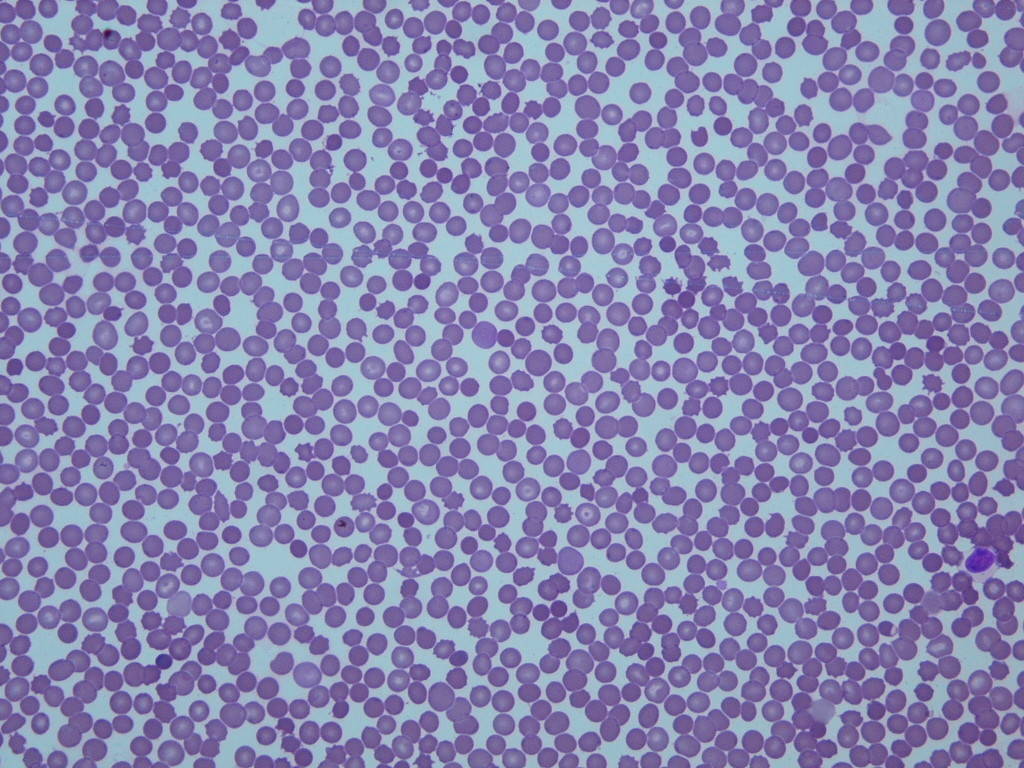
2_ホンドタヌキ.jpg
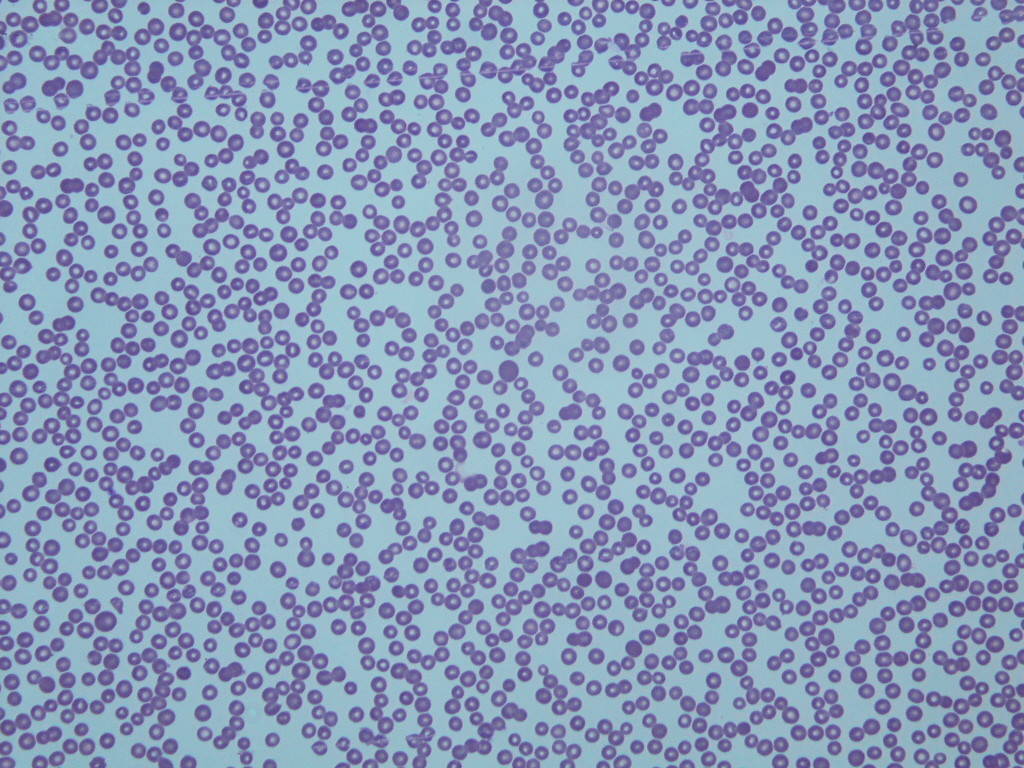
3_アミメキリン.jpg
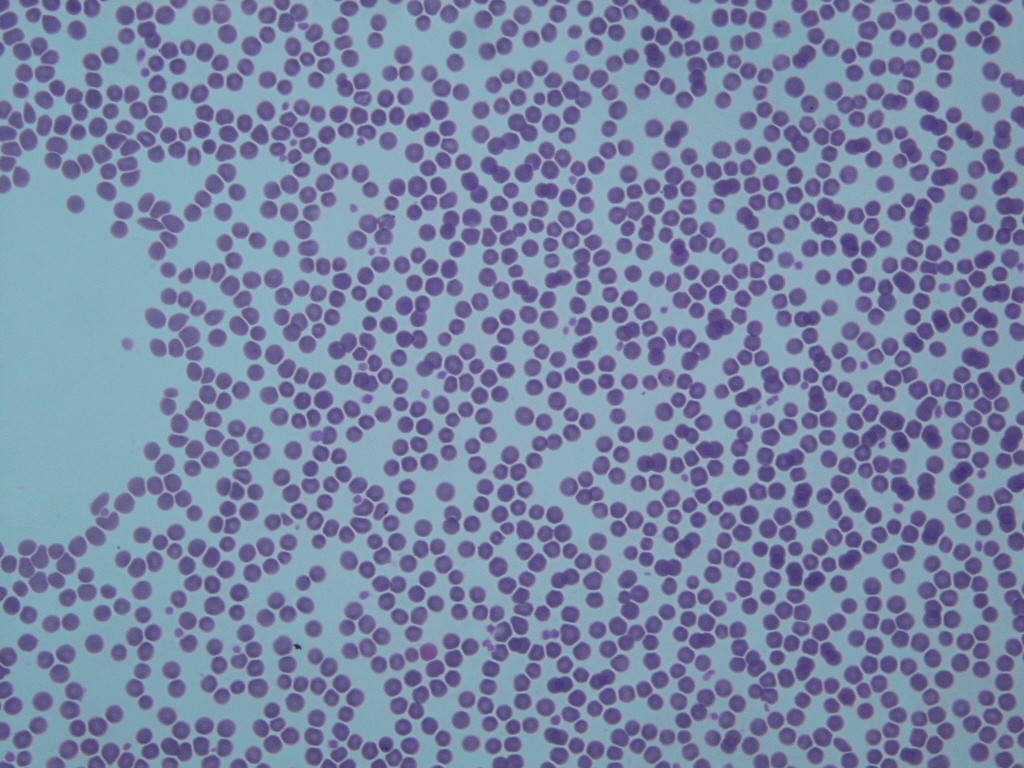
4_キツネザル.jpg
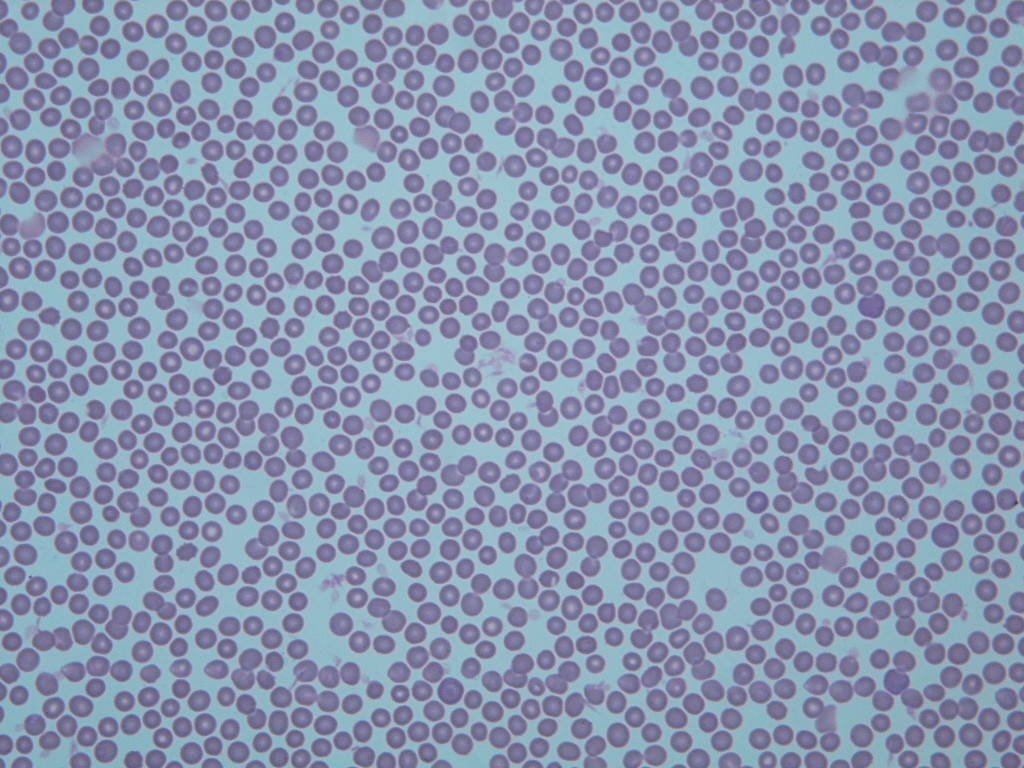
5_モルモット.jpg

更新日:2018.11.13いろいろな動物の赤血球のお姿 1. 哺乳類編
更新日:2018.11.13
いろいろな動物の赤血球のお姿 1. 哺乳類編
みなさんこんにちは。日々秋深まる今日この頃、いかがお過ごしでしょうか。
さて!動物病院では、園内の動物達の健康管理のために動物の血液を検査します。今回は、その一部のご紹介として、いろんな動物の赤血球のお姿をお示しします。
赤血球は、体の隅々まで酸素を送り届けるのが専門のお仕事ですが、そのお姿は、動物の種類によってどのくらい違うのでしょうか?
では早速哺乳類から始めましょう。
写真は血液塗抹(とまつ)標本、全て同じ拡大倍率です。
インドライオン
ホンドタヌキ
いずれも食肉目ですが、大きさが違いますね。
アミメキリン
アカエリマキキツネザル
モルモット
いずれも草食、アミメキリンが一番小さく、中央の凹みが明瞭ですね。
今回お示しした動物では、肉食と草食共に、大きな体の動物の方が、赤血球が小さいですね。ところが、比較血液学(そんな学問があるのー?)を勉強してみると、もっと大きなゾウやクジラの赤血球は、もっと大きいそうですよ!興味が湧いてきた方は、是非調べてみてください。
次は鳥類に続きます。
(飼育展示係 宗正)